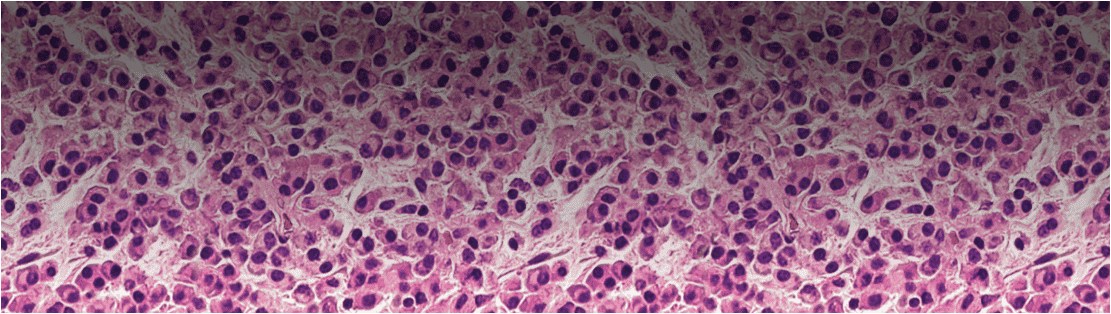
Comprendere il Mieloma Multiplo
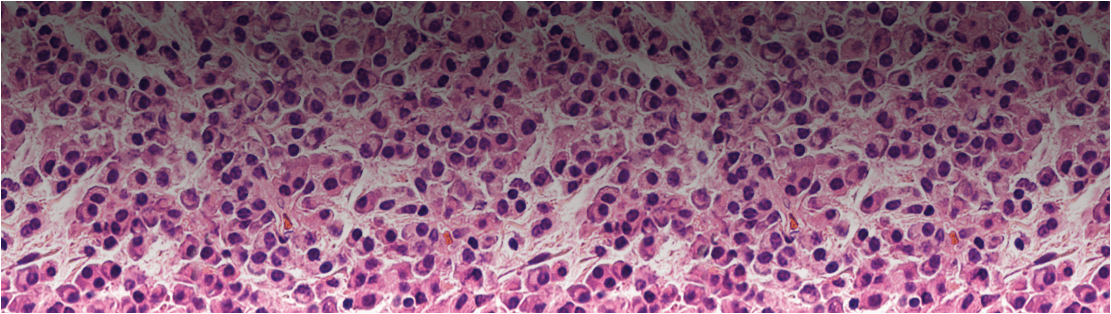
Comprendere il Mieloma Multiplo

Una diagnosi di mieloma multiplo si basa su una serie di caratteristiche cliniche e biomarker.1
I sintomi del mieloma multiplo sono spesso vaghi e includono dolore muscoloscheletrico e stanchezza.2 La presentazione dei sintomi, il decorso della malattia e il comportamento clinico variano notevolmente da paziente a paziente.3 A causa di questa natura eterogenea, può rivelarsi difficile per un Medico di Medicina generale (MMG) decidere quando indirizzare i pazienti con sospetto di mieloma multiplo a una visita specialistica ematologica.2 Di conseguenza, i pazienti affetti da mieloma multiplo hanno maggiori probabilità di altri pazienti affetti da forme tumorali di essere stati visitati da un MMG tre o più volte prima di essere inviati ad una visita specialistica. Un altro percorso diagnostico è la diagnosi di emergenza, che di solito è associata a prognosi più sfavorevole.2,3

FISH, Fluorescent In Situ Hybridization, ibridizzazione fluorescente in situ; FLC, free light chain, catena leggera libera; Ig, immunoglobulina; M, monoclonale; MRI, risonanza magnetica per immagini; PET-TC, tomografia a emissione di positroni con tomografia computerizzata; TC, tomografia computerizzata.
La presentazione e la progressione della malattia possono variare in modo significativo da paziente a paziente.1,3
Sintomi meno comuni
Sintomi meno comuni (che si verificano nel 5% dei pazienti) includono plasmocitomi extramidollari dei tessuti molli o compressione del midollo spinale a seguito di fratture vertebrali.4
I pazienti possono anche presentare infezioni batteriche ricorrenti; circa un terzo dei pazienti vengono diagnosticati in seguito a indagini sull'elevata velocità di sedimentazione di eritrociti, proteine totali o immunoglobuline.4
I pazienti con un aumento della proteina monoclonale (M) possono manifestare mal di testa, sanguinamento dal naso, confusione e visione offuscata.4
Presentazione dei sintomi
Alcuni pazienti possono richiedere una visita al proprio medico di famiglia a causa di sintomi non specifici, come affaticamento o mal di schiena, mentre altri possono presentarsi al pronto soccorso con sintomi acuti come una frattura delle ossa lunghe o una compressione spinale.4
Sebbene ogni paziente possa presentarsi in modo molto diverso, la diagnosi di mieloma multiplo sintomatico richiede che siano soddisfatti una serie di criteri specifici.1
I pazienti devono avere almeno il 10% di plasmacellule clonali del midollo osseo o plasmocitoma osseo o extramidollare dimostrato da biopsia e uno o più eventi che definiscono il mieloma:1
Criteri 'CRAB'* che forniscono prove di danni agli organi bersaglio correlati al disturbo delle plasmacellule alla base della malattia:3
Presenza di uno qualsiasi o di più biomarker di neoplasia:3
* La sigla CRAB deriva dalle lettere iniziali dei 4 criteri in lingua inglese: Calcium levels elevated, Renal insufficiency, Anaemia, Bone lesions
il mieloma smouldering può essere distinto dal mieloma sintomatico se un paziente ha livelli di proteina M sierica ≥30 g/L o li velli di proteina monoclonale urinaria ≥500 mg ogni 24 ore e/o il 10-60% di plasmacellule clonali del midollo osseo, in assenza di eventi che definiscono il mieloma o di amiloidosi.1
Non tutti i pazienti con mieloma multiplo hanno livelli elevati di proteina M sierica o urinaria.5
Per questo motivo, la presenza della proteina M non è richiesta per la diagnosi di mieloma multiplo, ma viene utilizzata solo per distinguere tra le tipologie secretoria e non secretoria.1
Anche con significativi progressi nel trattamento, il mieloma multiplo rimane una malattia difficile.
Scopri di più su questo tipo di tumore e sulla sua fisiopatologia.